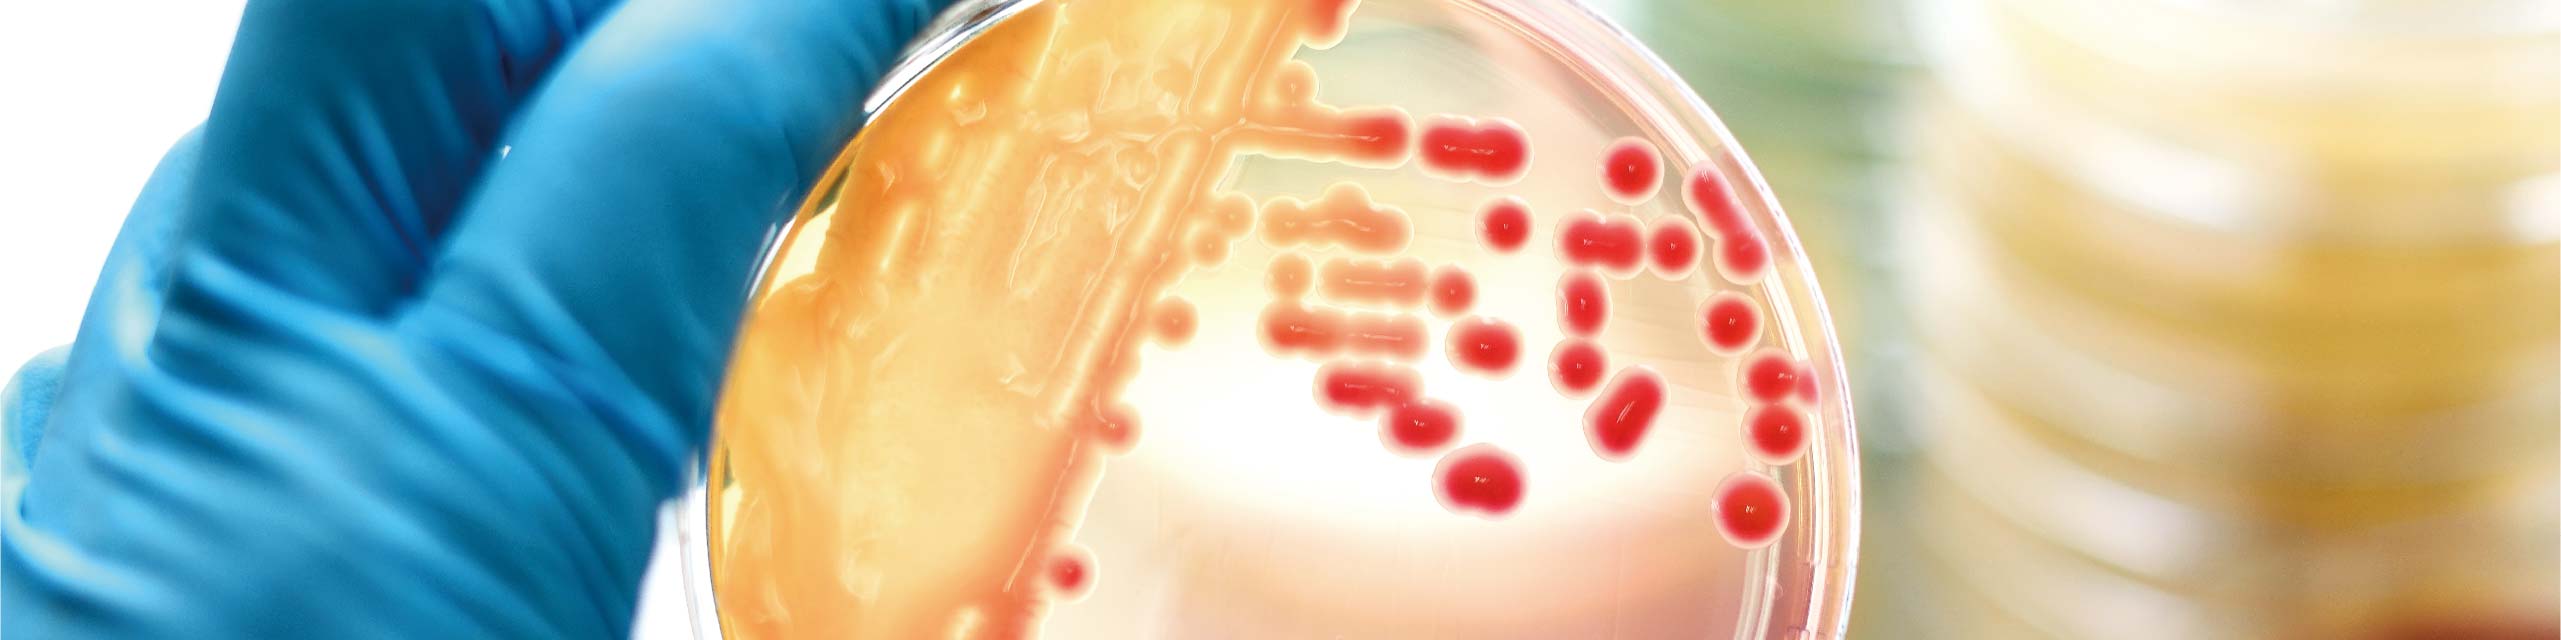

Anwendungen
Der Fermentationsprozess könnte Nahrungsmittelzutaten, Futtermittelzutaten, biochemische, biopharmazeutische und biolandwirtschaftliche Materialien nachhaltig produzieren, indem Bakterien, Hefe, Pilze und tierische Zellen als Produktionswert verwendet werden. Angel verfügt über ein komplettes Portfolio an Hefe-basierten Nährstoffen, maßgeschneiderten Nährstoffen, um den vielfältigen Nährstoffbedarf für jede spezifische Fermentationsindustrie zu erfüllen
Verwandte Blog









